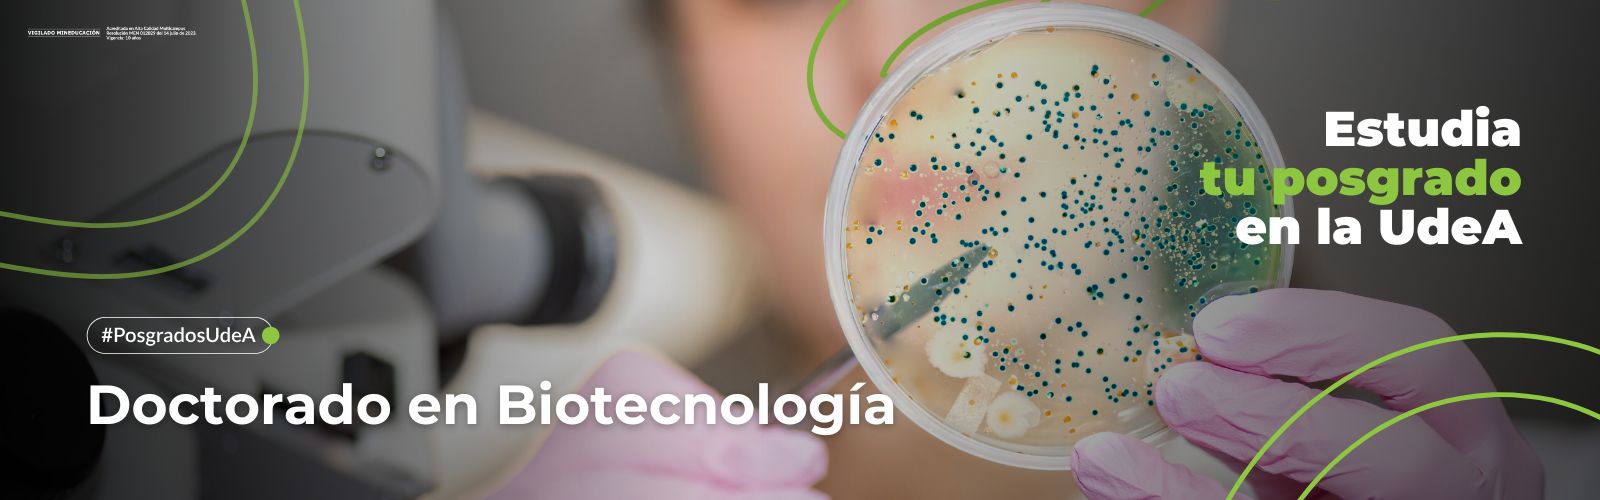

Portal U de A - Cabezote - WCV(JSR 286)
Signpost
Posgrados
Portal U de A - Visor de Contenido - WCV(JSR 286)
Portal U de A - Visor de Contenido - WCV(JSR 286)
UdeA - Información Menú - WCV(JSR 286)
Presentación
|
Código SNIES:
|
54787
|
|
Número total de créditos:
|
120
|
|
Titulo que otorga:
|
Doctor en Biotecnología
|
|
Duración:
|
8 semestres
|
|
Modalidad:
|
Doctorado (investigación)
|
|
Lugar donde se ofrece:
|
Medellín
|
|
Metodología:
|
Presencial, mediado por TICs.
|
|
Horario:
|
Definido de acuerdo con la programación de oferta curricular dentro de estas franjas diarias y horarias 6:00 am-21 horas, lunes-sábado.
|
|
Periodicidad:
|
Semestral
|
|
Inversión por semestre:
|
Cinco (5) salarios mínimos mensuales legales vigentes. Ver guía de pago
|
|
Registro calificado:
|
Resolución 14440, 25 de Agosto del 2023 por 7 años |
Resolución Apertura de cohorte 2025-2
El Programa de Doctorado en Biotecnología cuenta con Registro Calificado otorgado por el Ministerio de Educación Nacional mediante Resolución N° 10722 del 01 de junio de 2016 y código del SNIES N° 54787 del 14 de agosto del 2009, siendo titular del Registro la Universidad de Antioquia para ser ofrecido en convenio con la Universidad Católica de Oriente y Universidad de Pamplona.
Objetivo general:
El objetivo general del Programa de Doctorado en Biotecnología es formar investigadores de alto nivel, con capacidad de identificar problemas, proponer soluciones y llevarlas a cabo con el mayor rigor científico, en el área de la Biotecnología, incluyendo tanto la ciencia básica como la aplicada. Investigadores íntegros y competentes para interactuar con pares nacionales e internacionales y que posean los conocimientos conceptuales, técnicos y tecnológicos para generar conocimiento, nuevas teorías e impulsar el desarrollo de la comunidad científica, liderando y formando nuevos grupos de investigación.
Objetivos específicos:
Académicos
- Formar investigadores íntegros de alto nivel con capacidad de identificar problemas, proponer soluciones y llevarlas a cabo con el mayor rigor científico, incluyendo tanto la ciencia básica como la aplicada.
- Fomentar en los estudiantes la habilidad y liderazgo necesarios para realizar investigación en forma interdisciplinaria, bien sea en el entorno nacional o internacional.
- Promover en los estudiantes la conciencia de uso sostenible de la biodiversidad y la generación del conocimiento.
Investigativos
- Fortalecer las líneas y grupos de investigación que participan en el Doctorado en Biotecnología, con miras a la creación de nuevos grupos y al fomento del trabajo inter y trans disciplinario con otros grupos, tanto nacionales como internacionales.
- Incentivar la aplicación práctica de la investigación biotecnológica en temas de relevancia nacional, fortaleciendo las relaciones existentes con instituciones de investigación del sector privado y gubernamental.
- Propiciar una formación investigativa integral a través de equipos interdisciplinarios con estudiantes y profesionales de otras áreas para desarrollar proyectos conjuntos que brinden soluciones biotecnológicas a problemas reales plenamente identificados que representen un real impacto social.
- Otros objetivos son definidos por cada una de las líneas de investigación y proyectos de investigación que sustentan los cupos para los estudiantes.
Sociales
- Promover la importancia del conocimiento y utilización de la Biotecnología en el ambiente nacional, mediante el aumento de exigencia en la formación investigativa, con miras a la generación de alternativas socio-económicas para el país.
- Fomentar la relación de colaboración interinstitucional, intergrupal e interpersonal, con miras al fortalecimiento de los valores y la solución de las debilidades individuales.
- Aumentar el número y calidad de investigadores en el área Biotecnológica en el país, quienes a su vez puedan ser multiplicadores del conocimiento a través de la formación de nuevos investigadores y fortalecedores de los programas de Ciencia y tecnología, siendo así ejes de la transformación social.
Perfil aspirante:
Pueden aspirar al Programa de Doctorado todos los profesionales que acrediten título profesional emitido por una entidad de educación superior oficialmente reconocida por el Ministerio de Educación Nacional en: Biología, Biotecnología, Microbiología, Agronomía, Bioingeniería, Ingeniería Forestal, Ingeniería Biológica, Medicina Veterinaria y Licenciatura en Biología o en áreas relacionadas con: Biotecnología; Sistemática de la diversidad; Ecología de poblaciones, comunidades y ecosistemas; Genética, Biología Celular y Molecular y Área de las bases Biológicas de la Medicina.
Perfil egresado:
La formación ofrecida por el Doctorado en Biotecnología, permite a sus egresados ser altamente competentes en la identificación de oportunidades Biotecnológicas, su utilización en la solución de problemas de impacto ecológico, social, industrial y económico, y en la formulación, planteamiento y desarrollo de proyectos de investigación básica y aplicada. Adicionalmente, son competentes para la generación, asimilación y transmisión de nuevo conocimiento. Lo anterior capacita al egresado para que su desempeño le permita impactar positivamente, entre otros, los sectores investigativo, productivo y educativo, propiciando una transformación socio-económica en la región y el país.
Perfil ocupacional:
Luego de revisar los perfiles de egreso, las tendencias, entornos y necesidades del país frente a la Biotecnología, en el contexto del Estudio de Pertinencia adelantado, se logró establecer los siguientes espacios laborales para los egresados del Doctorado en Biotecnología, tanto en el sector público como privado:
- Investigador en centros de investigación de diferentes áreas.
- Docente en Instituciones de Educación Superior.
- Como independiente, prestando servicios, asesorías y consultarías a nivel industrial.
- Investigador, director, coordinador y jefe de centros de biotecnología, laboratorios de microbiología, laboratorios de análisis químicos laboratorios de farmacología, laboratorios de control de calidad, laboratorios de microbiología, centros de Investigación y Desarrollo, epidemiologia, entre otros.
- Líder e investigador en la industria farmacéutica, agroalimentaria, veterinaria, petroquímica y/o medioambiental, entre otros.
- Innovación en procesos de microbiología, genética, biorremediación, diagnóstico molecular, inmunología.
Resultados de Aprendizaje:
- Argumentar los conocimientos científicos y apropiarse de las bases conceptuales en las áreas básicas de la biotecnología y aquellas relaciona directamente con el tema de la Tesis Doctoral.
- Demostrar las habilidades y destrezas necesarias para llevar a cabo investigaciones biotecnológicas con alto rigor científico.
- Seleccionar y discutir artículos científicos relacionados con la Propuesta Doctoral, validando las habilidades de comunicación y transmisión de conocimientos en el contexto de los cursos y seminarios electivos.
- Formular la Propuesta Doctoral basada en la identificación de problemas reales y la formulación de hipótesis, objetivos, estrategias y métodos de investigación biotecnológica que lleven a la generación de nuevo conocimiento para la solución de problemas, innovación y/o generación de alternativas socio económicas biotecnológicas.
- Descubrir y debatir los componentes bioéticos y legales relacionados y pertinentes a la Propuesta Doctoral que lleven al uso sostenible de la biodiversidad.
- Sustentar la Propuesta Doctoral en el contexto de la Evaluación Comprensiva, argumentando su hipótesis y objetivos, interpretando los resultados obtenidos a la fecha y concluyendo a partir de ellos.
- Investigar, experimentar y concluir a partir de los resultados obtenidos en la investigación.
- Revisar y validar los conceptos, diseños experimentales e interpretaciones de los resultados mediante el diálogo de inter y trans disciplinar entablado en las reuniones semestrales con el Comité Asesor.
- Investigar, comparar y contrastar las interpretaciones y conclusiones de los resultados mediante el diálogo de inter y trans disciplinar entablado en el contexto de la Pasantía de Investigación.
- Construir la Tesis Doctoral discutiendo, argumentando y concluyendo a partir de los resultados de la investigación, contrastando, refutando o validado las conclusiones a la luz de la literatura científica relacionada.
- Defender la Tesis Doctoral mediante el diálogo de saberes inter y trans disciplinar entablado con el Jurado Evaluador.
- Difundir el conocimiento generado en el contexto de la Tesis Doctoral mediante la publicación de artículos científicos.


